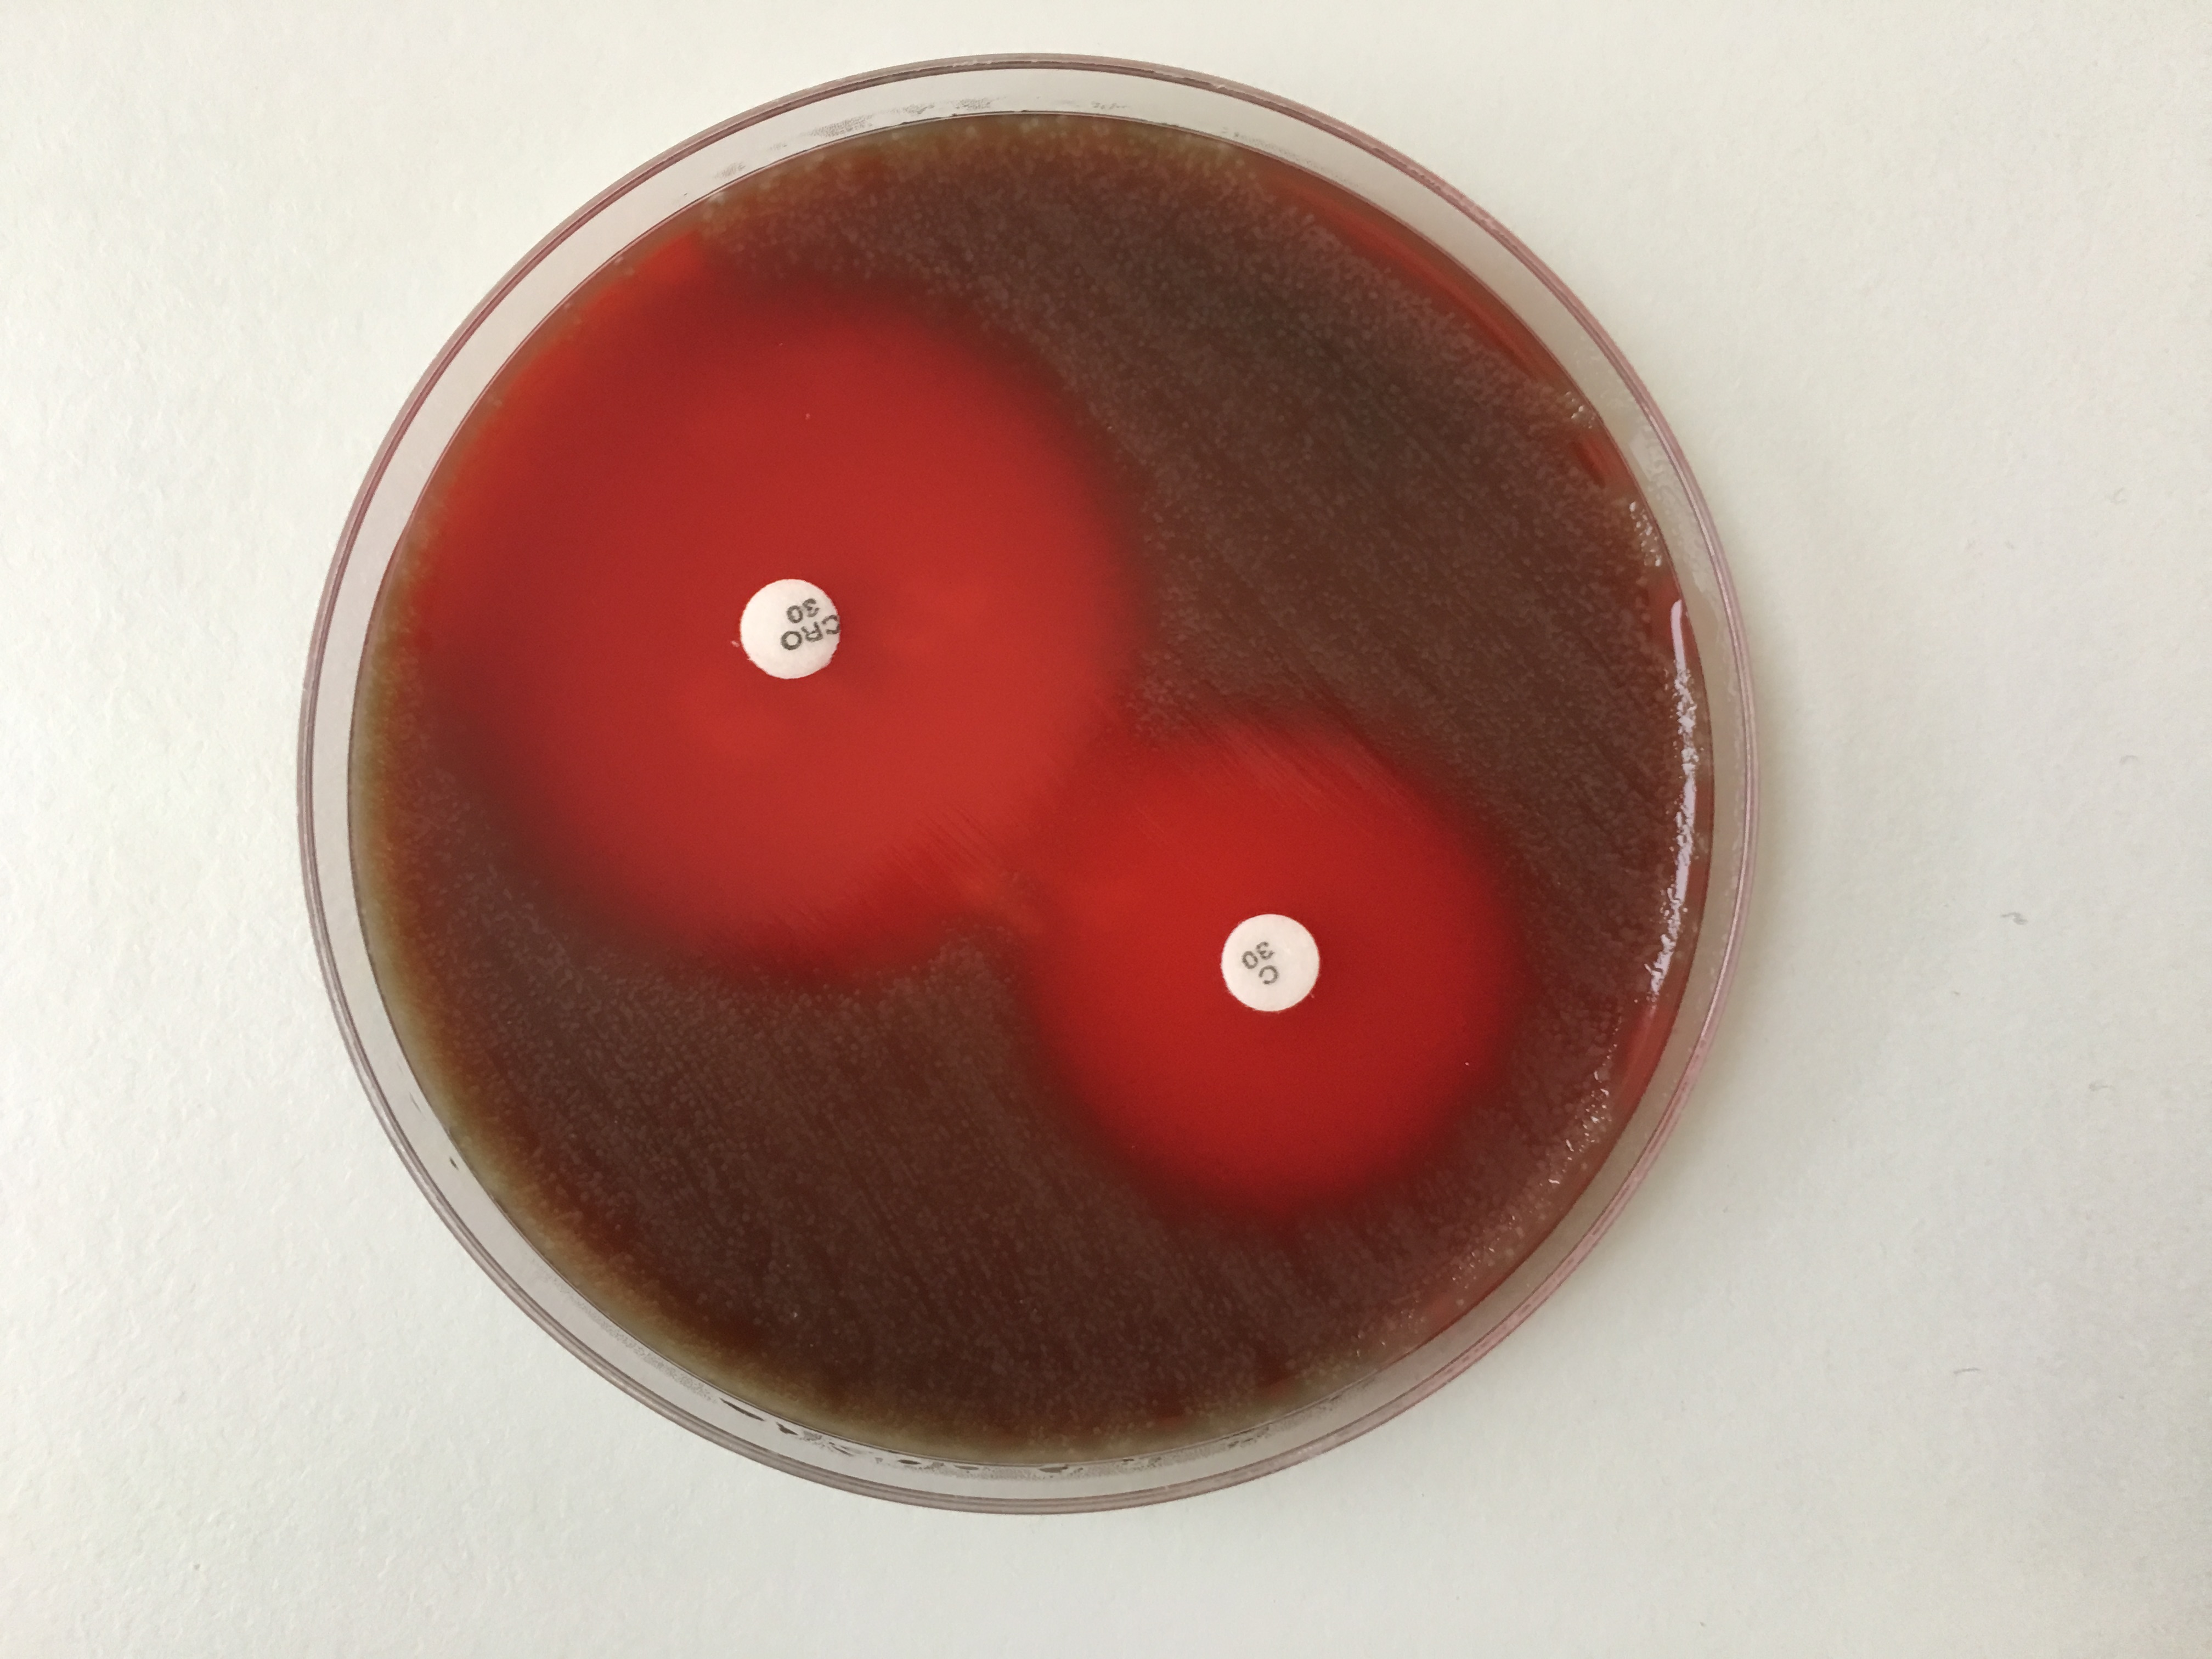

À propos du produit
La gélose Mueller Hinton II + 5% de sang de mouton est un milieu conçu pour tester la sensibilité aux médicaments des bactéries fastidieuses par la méthode de diffusion en disque (méthode Bauer-Kirby), selon les normes du Clinical and Laboratory Standards Institute (CLSI) à partir de colonies bactériennes isolées provenant d’échantillons cliniques humains.
La fonction du milieu est d’étayer le diagnostic en déterminant le profil de sensibilité/résistance aux antimicrobiens des bactéries fastidieuses isolées à partir d’échantillons cliniques.
L'antibiogramme utilisé dans le traitement des infections et la détermination du mécanisme de résistance de l'agent pathogène détecté dans un échantillon clinique permettent de prendre la bonne décision, individuelle, pour le patient en ce qui concerne le choix d'une antibiothérapie appropriée et efficace.
La méthode de diffusion sur disque selon CLSI est basée sur la méthode décrite par l’International Collaborative Study of Antimicrobial Sensibility Testing en 1972 (Etude collaborative internationale des tests de sensibilité aux antimicrobiens). En raison de sa simplicité d’exécution, cette méthode est la méthode la plus largement utilisée pour tester la sensibilité bactérienne aux médicaments dans les laboratoires médicaux. L’exécution correcte et normalisée du test selon la méthode CLSI et l’obtention de résultats fiables nécessitent l’utilisation de cette méthode sans modification, y compris l’utilisation du milieu spécifié par CLSI.
Selon les procédures CLSI, la gélose Mueller Hinton II + 5% de sang de mouton est un moyen de déterminer le profil de sensibilité aux médicaments des bactéries fastidieuses, en particulier du genre Streptococcus. La gélose Mueller Hinton II + 5% de sang de mouton est recommandée pour tester la résistance aux antibiotiques de Streptococcus pneumoniae suivants : chloramphénicol, érythromycine, ofloxacine, tétracycline et vancomycine, en plus du dépistage de la sensibilité à la pénicilline.